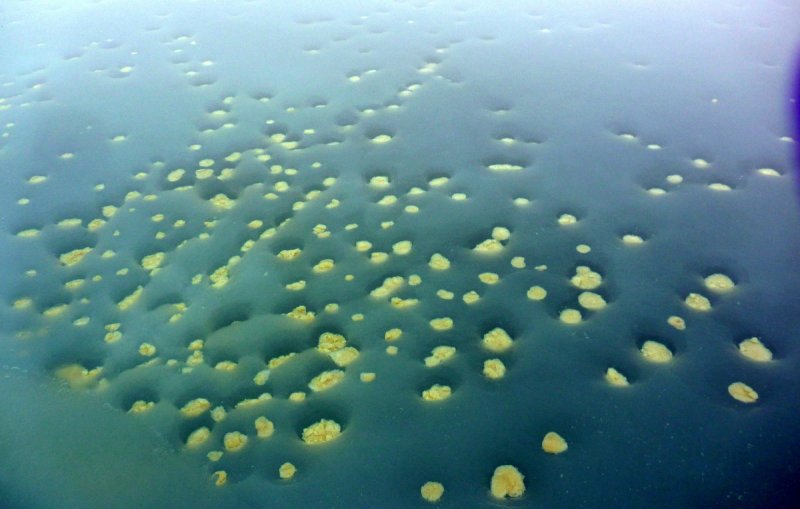
Remains of ice-algae, deposited at the bottom of a partially open melt pond.
(c) Mar Fernández-Méndez

Melting of sea ice may cause juvenile polar cod to starve
environmentmarine conservationpolar codice algaearctic ecosystem
0 views - 0 viewers (visible to dev)

The polar cod (Boreogadus saida) in the Arctic.
(c) Alfred-Wegener-Institut/Hauke Flores
Biologists verify polar cod's strong dependence on ice algae
The humble polar cod plays an integral role in the Arctic food web. They feed on amphipod crustaceans (Apherusa glacialis); and in turn, whales, seals and seabirds feed on them. However, a new study, recently published in the Progress in Oceanography journal, has verified that if things do not improve, the polar cod may soon find itself missing from the food web – thanks to the depletion of ice algae due to retreating sea ice.
For young polar cod that are one to two years old, the Arctic is a nursery where they live in cracks and crevices under the ice. They drift along with the ice, preying on amphipod crustaceans, which in turn feed on ice algae. This indirect relationship between the polar cod and ice algae has implications for the fish's long-time survival. This was the conclusion of a study by an international team of researchers from the Alfred Wegener Institute (AWI), Helmholtz Centre for Polar and Marine Research.
" Generally speaking, our findings indicate that polar cod are heavily dependent on ice algae," said first author and AWI biologist Doreen Kohlbach. "That means the rapid retreat of Arctic sea ice poses an especially serious threat for polar cod. When the ice retreats, it takes with it the basis of their diet. Given the polar cod’s pivotal role, this could also produce changes throughout the entire food web. "
For the study, the team undertook an expedition lasting several weeks to the Arctic Ocean on board the research vessel Polarstern. They dragged a specially designed under-ice net alongside the ship when they were between Greenland, Spitsbergen and Russia, and then analysed the stomach contents of the fish that were caught.
The stomach contents revealed that amphipod crustaceans formed the bulk of the polar cod's diet. In turn, amphipod crustaceans feed on diatoms that grow on or under the sea ice.
Next, the scientists confirmed the presence of carbon from the ice algae in the fish by analysing the fatty-acid patterns and the composition of stable isotopes in the fish's muscles and other tissues. (Some fatty acids are passed on unchanged from the algae to the animals that consume them.)
" When we find the fatty acids from the ice algae in the meat or tissues of a fish, it tells us the fish or its prey must have fed on the algae, " said Kohlbach. An isotope analysis was then used to determine the percise percentage of ice-algae carbon in the fish's diet.
" The analysis shows that diatoms make up the most important source of carbon for polar cod, " said Kohlbach. In fact, the outcomes indicate that between 50 and 90 percent of the young polar cod’s carbon stems from ice algae.
" Even though we had assumed there was a connection between the ice algae and polar cod from the outset of the study, these high values surprised us."
Last year, the researchers had already confirmed the importance of ice algae as a food source for animal species found mainly in deeper waters ( also see here ). This latest study now proves that this dependency also applies to the next link in the food chain.
Both studies have yielded valuable data that can be used in ecosystem models, which are essential in predicting how the Arctic ecosystem will be affected by the retreating sea ice.
See here for more information Link to the study
Remains of ice-algae, deposited at the bottom of a partially open melt pond.
(c) Mar Fernández-Méndez

The deployment of the SUIT net. It can dive under the sea ice to catch organisms living there.
(c) Jan van Franeker – IMARES